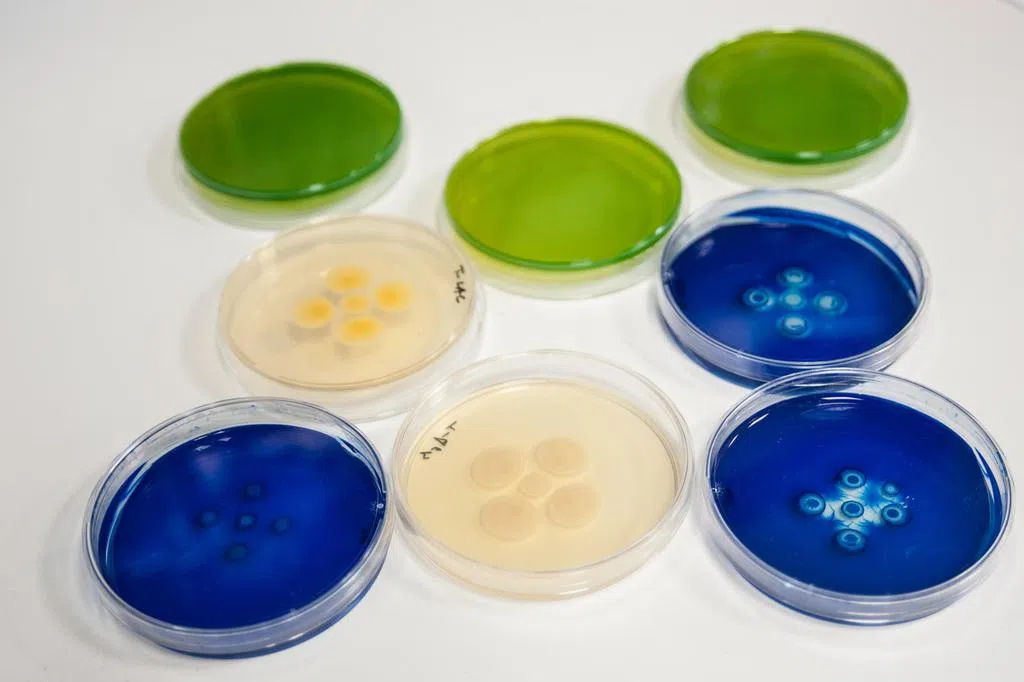

(华盛顿综合电)国际货币基金组织(IMF)说,尽管全球经济对美国关税表现出一定的韧性,但预计增长将持续疲软,而且容易受到贸易冲击的影响。
IMF星期二(7月29日)发表了《世界经济展望》报告的更新内容,认为受美国总统特朗普试图重塑国际贸易规则的影响,预计全球经济增长率将从2024年的3.3%放缓至2025年的3%。最新预测比4月份的预测高出0.2个百分点。
它指出,上调全球经济增长预期受多个因素影响,包括进口商因加征关税预期而提前囤货;当前美国平均有效关税率低于4月宣布的水平;美元走弱等因素推动金融环境改善;一些主要经济体实施财政扩张政策等。
IMF首席经济师古林查斯在记者会上说:“虽然贸易冲击可能没有最初担心的那么严重,但规模仍然相当可观,而且越来越多的证据表明,它正在损害全球经济。当前的贸易环境仍然不稳定。”
IMF勾勒出一幅阴云密布的经济前景,包括贸易协议可能破裂、不确定性对投资的影响、地缘政治紧张局势、公共债务高企以及美国通货膨胀压力加剧。
IMF说:“预计全球经济增长将减速,贸易相关扭曲的韧性将减弱。即使关税率相对于基准税率假设保持不变,且没有出台新的保护主义措施,贸易政策不确定性的加剧也可能对经济活动造成更大压力。”
它指出,虽然美国已经与欧盟和日本等国家达成了贸易协议,但细节问题依然存在,而且特朗普也可能改变主意。预计2026年的经济增长将仅小幅回升至3.1%。
它也预计美国经济今年将增长1.9%,比4月的预测高出0.1个百分点。欧元区经济预计今年将增长1%。中国今年的增速预测被上调0.8个百分点至4.8%,因为中国今年上半年的经济活动强于预期,以及中美关税大幅下调。